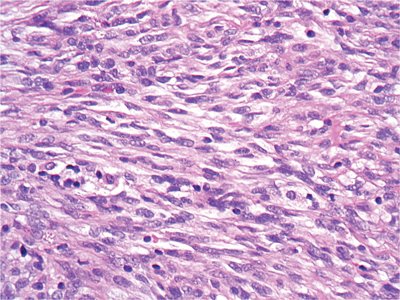

History
-
A 25-year-old West African male presents with oral candidiasis, generalised lymphadenopathy and a red nodule in the left upper eyelid.
-
This is biopsied.
-
See histology images.
Figure 1.

Figure 2.

Figure 3.
Questions
1. Describe Figure 1 (haematoxylin and eosin stain).
2. What does Figure 2 show (haematoxylin and eosin)?
3. Figure 3 is an immunohistochemical stain that is picking out the nuclei of the cells shown in Figures 1 and 2. Which protein is being stained for?
4. What is the likeliest diagnosis?
5. Why is this diagnosis rare to chance upon in routine practice these days?
Answers
1. A spindle cell neoplasm, composed of uniform cells with minimal nuclear pleomorphism.
2. This figure shows a ‘sieve-like’ pattern of the spindle cells cut end on, with erythrocytes in-between.
3. Human herpes virus 8 (HHV8).
4. This is Kaposi’s sarcoma.
5. This patient had AIDS secondary to HIV infection (hence the oral candida infection and generalised lymphadenopathy). Highly active anti-retroviral therapy is widely available worldwide and this has lead to diminishing rates of Kaposi’s sarcoma and other HIV associated morbidities.
COMMENTS ARE WELCOME

